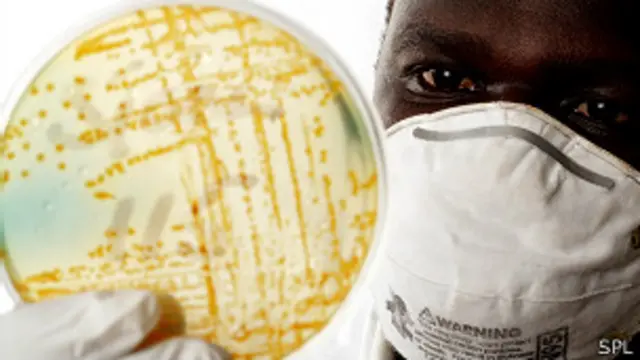
Investigación sobre el cólera

El pueblo genéticamente resistente al cólera
- Autor, Gabriela Torres
- Título del autor, BBC Mundo Salud
Durante milenios, el Delta del río Ganges, en Bangladesh, ha sido una fuente de cólera. Fue allí donde se originó la enfermedad que cada año afecta a entre tres y cinco millones de personas.
También es allí donde la población ha desarrollado una resistencia genética a la enfermedad, según un estudio publicado en la revista Science Translational Medicine.
Investigadores del Hospital General de Massachusetts, en Estados Unidos, y del Centro Internacional para Enfermedades Diarreicas, en Bangladesh, hicieron el hallazgo tras estudiar a 42 familias de la capital Dhaka, escogidas de forma aleatoria, y hacer un escáner de sus genomas.
"El objetivo era entender la arquitectura genética de la población en esa región y ver si podíamos encontrar evidencias en regiones del genoma que sugirieran una selección natural", le explica a BBC Mundo Regina LaRocque, co-jefa del ensayo.
Los expertos sabían que en poblaciones donde el cólera es endémico las personas tienden a contraer una forma menos severa de la enfermedad, y por ende tienden a morir menos, que en lugares donde el cólera es relativamente nuevo, como Haití.
El resultado fue la identificación de 305 regiones del genoma que han mutado -o evolucionado, como los especialistas prefieren llamarlo- para crear una mayor resistencia a la enfermedad. Tienen una versión diferente de ADN que los protege.
"Todavía no sabemos exactamente la importancia de esta diferencia", le aclara a BBC Mundo Elinor Karlsson, genetista y co-jefa de la investigación. "El siguiente paso es mirar más de cerca todos los genes de estas regiones e identificar el exacto cambio protector".
Lo que sí saben es que estas regiones están involucradas en dos funciones biológicas importantes: la regulación del paso de agua a través de células intestinales y la vía de señalización tanto en el sistema inmune innato como en el mantenimiento de la mucosa intestinal.
Versión "protectora"
Durante el trabajo también se comparó a 105 pacientes con cólera con 167 individuos que no se contagiaron a pesar de estar expuestos a la infección en sus propias casas. Los especialistas descubrieron que la región del genoma asociada con mayor fuerza a la susceptibilidad del cólera es donde -según el escáner del genoma- se produce una fuerte presión de selección.
"Lo que queremos decir con esto es que las personas con una versión 'protectora' de esta región del genoma sobrevivieron más -porque eran menos propensos a contagiarse- y pudieron tener más hijos. Algunos de esos hijos también llevaban ese cambio 'protector' por lo que tuvieron más niños y, con el tiempo, esa versión fue cada vez más común en Bangladesh", explica Karlsson.
Las autoras del estudio sostienen que con este trabajo han demostrado que la adaptación a las necesidades del sistema inmune probablemente juega un papel importante en cómo respondemos a las infecciones, algo que se está convirtiendo en un tema.

"Pienso que lo que encontramos en nuestro ensayo fue un tipo de moldeado en el sistema inmune innato que con el tiempo ha ocurrido en poblaciones como respuesta al cólera y quizás otros factores influyentes", señala por su parte LaRocque.
"No eliminan la enfermedad, pero sí la marginalizan de manera tal que la gente no se enferma tanto", agrega.
Elinor Karlsson confiesa que no saben exactamente cómo a un nivel celular hay individuos de la misma región que pueden ser más resistentes al cólera que otros.
"Probablemente sea un poco como la vacuna de la gripe. Si la recibes, puede que todavía te dé gripe, pero eres mucho menos propensa a contagiarte que otro que no se ha vacunado. Si te da gripe, entonces estarás menos enfermo que alguien sin la vacuna", explica la genetista.
Vacuna genética
Para las personas con una resistencia genética, es casi como nacer con una vacuna genética. Ellos heredan la versión de los genes de sus padres que les dé una protección al nacer.
"Como creemos que son muchos los genes involucrados, algunas personas pueden tener la versión completa de esa protección y ser muy resistentes, mientras que otros pueden heredar sólo una parte y tener una resistencia intermedia", aclara Karlsson. "Si logramos descubrir cómo funciona, podremos descifrar cómo proteger a la gente que nace sin ninguna protección genética".
Expertos consideran que las enfermedades infecciosas probablemente son uno de los mayores retos que la humanidad ha enfrentado durante los últimos 50.000 años.
Se estima que enfermedades como la lepra, tuberculosis y malaria, entre muchas otras, han estado entre nosotros durante mucho tiempo.
"En poblaciones expuestas a estas enfermedades, sus ADN han evolucionado para protegerlos", cuenta Karlsson.
Algunas enfermedades, como la lepra, llegaron a afectar a casi toda la población mundial y hoy en día la especialista calcula que el 95% de las personas es inmune a la bacteria que la causa.
Otras infecciones, como el cólera, han estado restringidas a ciertas áreas del mundo.









